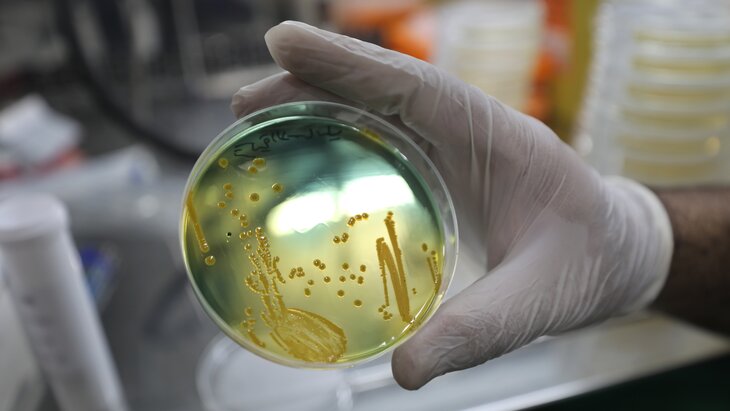

06 июля 2023, 18:04
ОбществоРоспотребнадзор выявил холероподобную микрофлору в реке Темерник в Ростове-на-Дону
Фото: ТАСС/EPA/YAHYA NEMAH
Роспотребнадзор выявил типичную для жары холероподобную микрофлору в реке Темерник на территории Ростова-на-Дону, сообщается на сайте регионального ведомства.
Специалисты усилили мониторинг микробного загрязнения поверхностных водоемов и рек. Лабораторные исследования микрофлоры осуществляются Ростовским противочумным институтом Роспотребнадзора и РосНИПЧИ "Микроб".
"Введено ограничение водопользования (купание, ловля рыбы, использование воды для хозяйственных нужд) в реке Темерник, Ростовском море и Северном водохранилище до завершения полного комплекса лабораторных исследований", – говорится в сообщении.
Кроме того, в городе провели собрание санитарно-противоэпидемической комиссии. По итогам заседания были одобрены меры по недопущению осложнения эпидобстановки. Сейчас в регионе она стабильная, уточнили в ведомстве. Общие показатели инфекционной заболеваемости не превышают среднемноголетних значений.
На этом фоне жителям рекомендовали строго соблюдать правила личной гигиены, купаться лишь в разрешенных местах, употреблять только гарантированно безопасную воду и напитки, не покупать продукты в местах несанкционированной торговли, а также соблюдать раздельную переработку сырых и вареных продуктов.
Накануне ведомство зафиксировало несколько случаев заболевания менингококковой инфекцией у сотрудников Ozon в Екатеринбурге. Позже стало известно, что два сотрудника погибли.








Собянин: завершается строительство станции метро "Бульвар Генерала Карбышева"



























